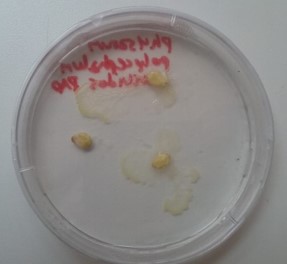

*16.10.2018
- General introduction of the course and the working norms inside the laboratory.
- Lectures: The new vision 1928 fourth revised edition 1947 and abstract of an Artist by László Moholy-Nagy & Generation M. Matter, Markers, Microbiomes::Compost for Gaia. Dimitris Papadopoulos.
- Preparation of the environment for the first bacteria crop in Petri box. two fingerprints and an A figure with the sample bacterias of Nizar mouth.
*23.10.2018
- Diskussion about the lectures from the first class.
- Presentation about etichs.
- Observation under microskope of existing specimens in the laboratory.
- Farming of new specimen in Petribox. Polycephalum/physarum. The first one with living specimens, the second one with sleeping specimens. After the first night they started to grow.
- Day 2, both specimens grow up in the darkness with a temperature of 20°C. The first specimens were closer to the food and have 5 leaflets, and they started to grow on top of it. The second specimens were farther from the food, and have just 3 leaflets, they grew in the direction of the food.